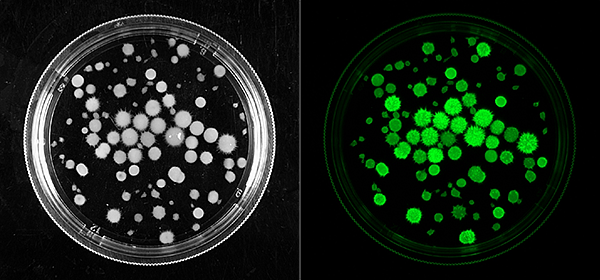

- Александр Новиков Жизненный цикл Кол-во комментариев: 34 18:38 / 12 мая 2018
- Машины и Механизмы Новый алкогольный закон Кол-во комментариев: 37 13:48 / 02 июля 2012
- Евгений Арчишаускас Медицина для космонавтов Кол-во комментариев: 15 23:53 / 12 января 2018
 МАИ
МАИ
 СГМУ имени В. И. Разумовского
СГМУ имени В. И. Разумовского
 Машины и Механизмы
Машины и Механизмы
 СГМУ имени В. И. Разумовского
СГМУ имени В. И. Разумовского
 СПбГЭТУ «ЛЭТИ»
СПбГЭТУ «ЛЭТИ»
 Машины и Механизмы
Машины и Механизмы
 СГМУ имени В. И. Разумовского
СГМУ имени В. И. Разумовского
 ПНИПУ
ПНИПУ
 Машины и Механизмы
Машины и Механизмы
 ПНИПУ
ПНИПУ
 СГМУ имени В. И. Разумовского
СГМУ имени В. И. Разумовского
 СГМУ имени В. И. Разумовского
СГМУ имени В. И. Разумовского
 ПНИПУ
ПНИПУ
 НИЯУ МИФИ
НИЯУ МИФИ
 Машины и Механизмы
Машины и Механизмы
 СГМУ имени В. И. Разумовского
СГМУ имени В. И. Разумовского
 СГМУ имени В. И. Разумовского
СГМУ имени В. И. Разумовского
 Машины и Механизмы
Машины и Механизмы
 ПНИПУ
ПНИПУ
 ПНИПУ
ПНИПУ
 СГМУ имени В. И. Разумовского
СГМУ имени В. И. Разумовского
 МФТИ
МФТИ
 Машины и Механизмы
Машины и Механизмы
 ПНИПУ
ПНИПУ
 ПНИПУ
ПНИПУ
 СГМУ имени В. И. Разумовского
СГМУ имени В. И. Разумовского
 СГМУ имени В. И. Разумовского
СГМУ имени В. И. Разумовского
 СГМУ имени В. И. Разумовского
СГМУ имени В. И. Разумовского
 СГМУ имени В. И. Разумовского
СГМУ имени В. И. Разумовского
 Машины и Механизмы
Машины и Механизмы
 Машины и Механизмы
Машины и Механизмы
 ПНИПУ
ПНИПУ
 СПбГЭТУ «ЛЭТИ»
СПбГЭТУ «ЛЭТИ»
 ПНИПУ
ПНИПУ
 Машины и Механизмы
Машины и Механизмы
 ПНИПУ
ПНИПУ
 СГМУ имени В. И. Разумовского
СГМУ имени В. И. Разумовского
 Машины и Механизмы
Машины и Механизмы
 СГМУ имени В. И. Разумовского
СГМУ имени В. И. Разумовского
 ПНИПУ
ПНИПУ
 Машины и Механизмы
Машины и Механизмы
-
В СПбГУ нашли способ предотвратить внезапную смерть от аневризмы брюшной аорты через анализ крови Ученые‑медики Санкт-Петербургского государственного университета разработали доступный метод оценки риска разрыва аневризмы брюшной аорты у мужчин старше 60 лет. Такой подход не требует дорогостоящего...

-
Пермский университет и РАН работают над созданием альтернативы химиотерапии на основе оксида графена Изучен противоопухолевый потенциал оксида графена. Научный коллектив Института экологии и генетики микроорганизмов УрО РАН и кафедры микробиологии и иммунологии биологического факультета ПГНИУ изучил влияние...

-
Ученые назвали месторождения бурого угля, содержащие наибольшее количество веществ, полезных для сельского хозяйства Ученые НИТУ МИСИС и Института проблем нефти и газа Сибирского отделения РАН исследовали якутские угольные бассейны и выявили месторождения с наибольшим содержанием гуминовых кислот — активных органических...